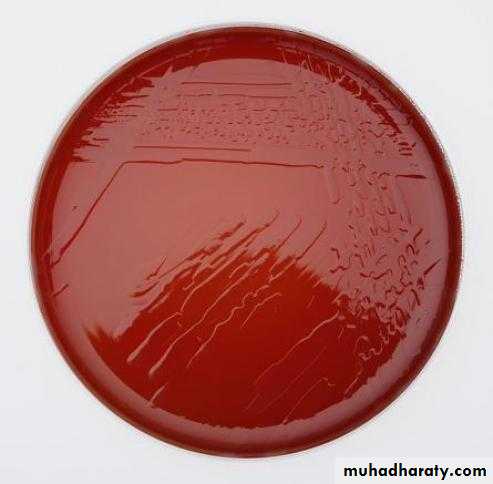

بسم الله الرحمن الرحيم
Campylo bacters
Campylobacters cause both diarrheal and systemic diseases.
Campylobacter infected domesticated animals also is widespread.
C jejuni is the prototype organism in the group and is a very common cause of diarrhea in humans.
Top five pathogens contributing to domestically acquired foodborne illness:
NorovirusSalmonella (non-typhoidal)
Clostridium perfringens
Campylobacter spp.
845,024 estimated illnesses
Staphylococcus aureus
Center for Food Security and Public Health, Iowa State University, 2012
Campylobacter jejuni
These bacteria are common assalmonellae and shigellae as a cause of diarrhea;
an estimated 2 million cases occur in the United States each year.
Morphology and Identification
Typical OrganismsC jejuni are G- rods with comma, S, or “gull wing” shapes.
They are motile, with a single polar flagellum, and do not form spores.
Culture
Selective media , incubation must be in an atmosphere with reduced O2 (5% O2) with added CO2 (10% CO2). MicroaerophilicIncubation of primary plates for isolation of C jejuni should be at 42°C.
Although C jejuni grows well at 36–37°C, incubation at 42°C prevents growth of most of the other bacteria present in feces
Several selective media are in widespread use. Skirrow’s medium contains vancomycin, polymyxin B, and trimethoprim to inhibit growth of other bacteria,
The colonies tend to be colorless or gray. They may be watery and spreading or round and convex, and both colony types may appear on one agar plate.
Growth Characteristics
C jejuni are oxidase + and catalase+.Campylobacters do not ferment carbohydrates.
Hippurate test +, hydrogen sulfide production, and antimicrobial susceptibilities can be used for further identification of species.
Antigenic Structure and ToxinsVirulence factors
* lipopolysaccharides with endotoxic activity.*extracellular toxins and
*enterotoxins, but the significance of the toxins in human disease is not defined.
Pathogenesis and Pathology
The infection is acquired by the oral route from food, drink, or contact with infected animals or animal products, especially poultry.C jejuni is susceptible to gastric acid, and ingestion of about 104 organisms is usually necessary to produce infection. This inoculum is similar to that required for Salmonella and Shigella infection but less than that for Vibrio infection.
The organisms multiply in the small intestine, invade the epithelium, and produce inflammation that results in the appearance of red and white blood cells in the stools,
the bloodstream is invaded, and a clinical picture of enteric fever develops. Localized tissue invasion coupled with the toxic activity appears to be responsible for the enteritis.
Clinical Findings
Clinical manifestations are acute onset of crampy abdominal pain, profuse diarrhea that may be grossly bloody, headache, and fever.Usually the illness is self-limited to a period of 5–8 days, but it continues longer.
C jejuni isolates are usually susceptible to erythromycin, and therapy shortens the duration of fecal shedding of bacteria.
Most cases resolve without antimicrobial therapy; however, in about 5–10% of patients, symptoms may recur.
• Certain serotypes of C jejuni have been associated with postdiarrheal Guillain-Barre syndrome, a form of paralytic disease.
• About 32% of person with GBS have diarrhial disease.
• Reactive arthritis and Reiter’s syndrome may also follow acute Campylobacter diarrhea.
• Reactive arthritis:
• Campylobacter
• Shigella
• Salmonella
• Chlamydia
• Ureaplasma
• Yersinia
•
Diagnostic Laboratory Tests
SpecimensDiarrheal stool is the usual specimen.
C jejuni may be recovered from blood cultures usually from immunocompromised or elderly patients.
Smears
Gram-stained smears of stool may show the typical “gull wing”–shaped rods.